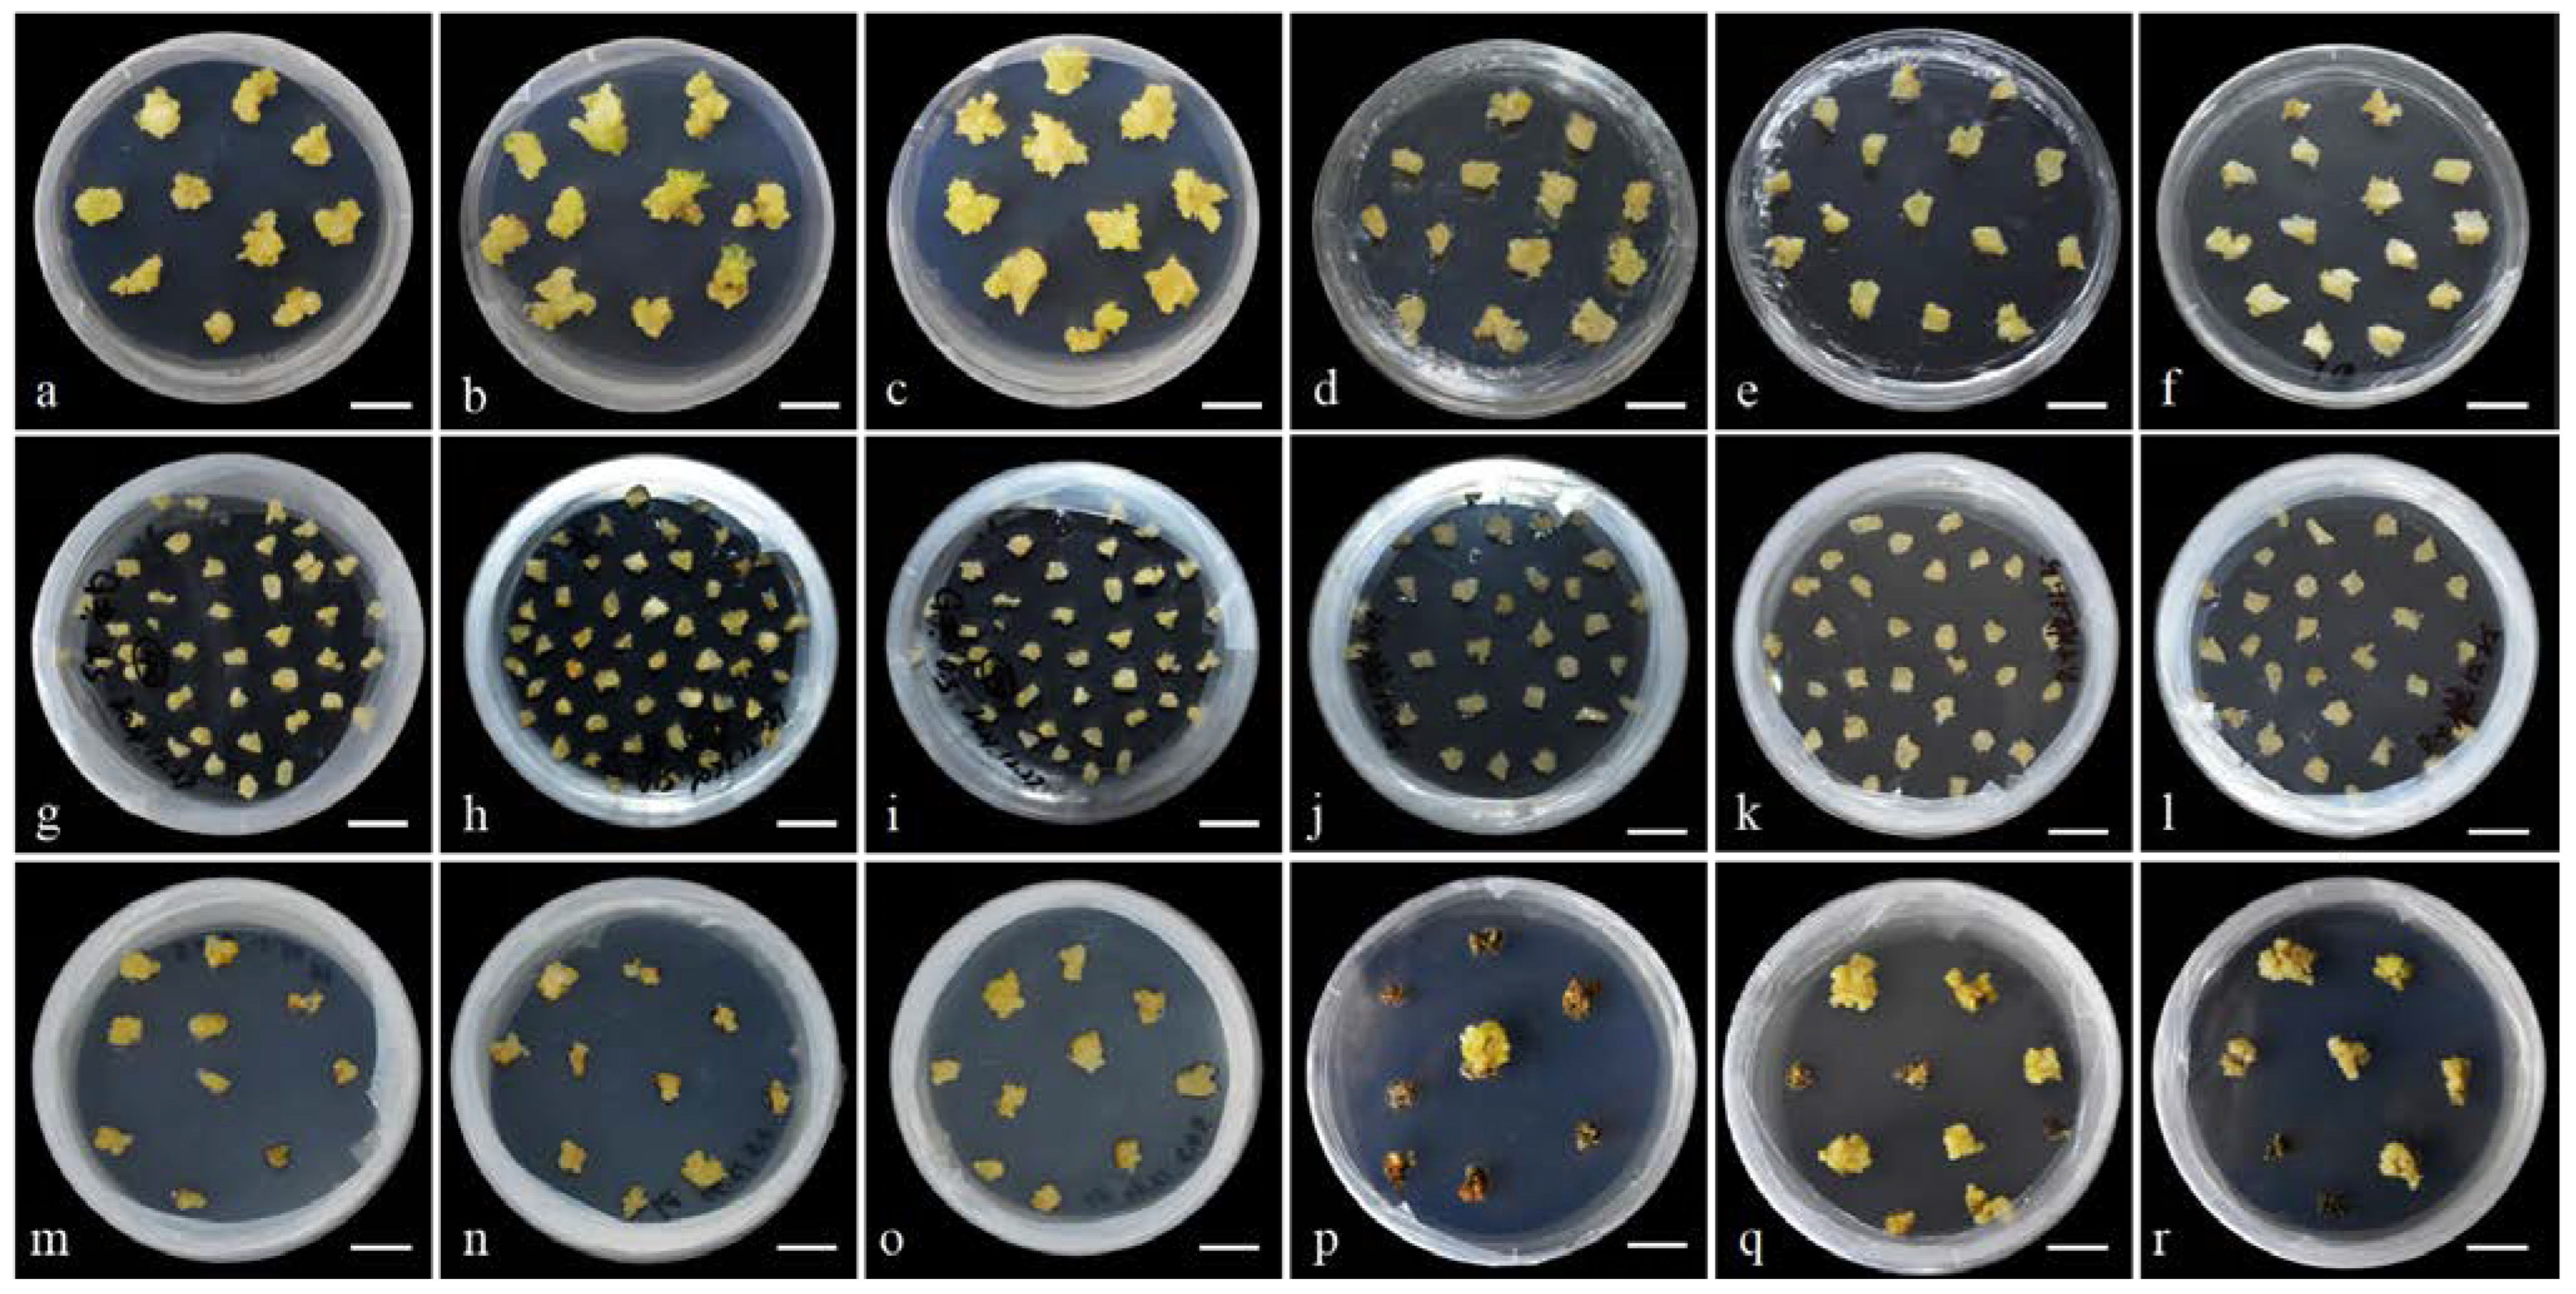
Horticulturae 11 00417 g004

Preliminary Establishment of an Efficient Regeneration and Genetic Transformation System for Hemerocallis middendorffii Trautv. & C. A. Mey.
Abstract
1. Introduction
2. Materials and Methods
2.1. Preparation of Media and Acquisition of Explants
2.2. Optimization of Plant Regeneration Conditions
2.2.1. Callus Induction, Proliferation, and Subculture
2.2.2. Differentiation and Rooting
2.3. Construction of Overexpression Vector and A. tumefaciens Strain for Transformation
2.4. Evaluation of the Factors Affecting Transformation Rate
2.4.1. Determination of the Tolerance of Calli to Hyg
2.4.2. Determination of the Tolerance of A. tumefaciens to TMT
2.4.3. Screening of AS Concentration
2.4.4. Screening of A. tumefaciens Optical Density
2.5. Transformation of Calli via A. tumefaciens Cells
2.6. Confirmation of Transgenic Plants
2.7. Formulas
2.8. Statistical Analysis
3. Results
3.1. Plant Regeneration Conditions
3.1.1. Effect of Seed Coat Treatments on Primary Culture
3.1.2. Establishment of the Callus Induction and Shoot Induction Protocol
3.2. Factors Influencing Agrobacterium-Mediated Transformation
3.2.1. Hyg Concentration
3.2.2. TMT Concentration
3.2.3. AS Concentration
3.2.4. Bacterial Cell Density
3.3. Stability Test of the H. middendorffii Transformation System
3.4. Validation of Transgenic Plants
4. Discussion
5. Conclusions
Supplementary Materials
Author Contributions
Funding
Data Availability Statement
Conflicts of Interest
References
- Chen, X.; Liang, S.; Xu, J.; Tamura, M.N. Flora of China; Science Press: Bejing, China; Missouri Botanical Garden Press: St. Louis, SK, Canada, 2020; pp. 73–263. [Google Scholar]
- Masuda, K.; Setoguchi, H.; Nagasawa, K.; Ishihara, M.; Sakaguchi, S. Development and characterization of EST-SSR markers for Amur daylily, Hemerocallis middendorffii Trautv. & C. A. Mey. (Asphodelaceae). Acta Phytotax. Geobot. 2021, 72, 73–78. [Google Scholar] [CrossRef]
- Liu, Y. The Establishment of Hemerocallis middendorfii Callus Induction and Agrobacterium Mediated Genetic Transofrmation System. Master’s Dissertation, Jilin Agricultural University, Changchun, China, 2016. [Google Scholar]
- Wang, H. Alleviating Effect of Exogenous Ca(NO3)2 on Hemerocallis middendorfii Under Salt Stress. Master’s Dissertation, Northeast Agricultural University, Harbin, China, 2022. [Google Scholar]
- Chen, L.F.; Liu, Y.Y.H.; Li, J.J.; Bai, Y.; Meng, Y.; Zhou, Y.W. Identification and analysis of bHLH transcription factor gene family in Hemerocallis middendorffii under drought stress. Southwest China J. Agr. Sci. 2023, 36, 1027–1038. [Google Scholar]
- Ren, Y.; Gao, Y.K.; Liu, J.J.; Fu, M.; Zhang, Q.X. Investigation on resources of Hemerocallis in North China. Acta Hortic. 2017, 1185, 65–72. [Google Scholar] [CrossRef]
- Wang, R. Effects of Three Plant Growth Regulators on the Growth and Development of Hemerocallis middendorfii. Master’s Dissertation, Northeast Agricultural University, Harbin, China, 2023. [Google Scholar]
- Shen, P. Genetic Diversity of Hemerocallis middendorfii in North-East of China. Master’s Dissertation, Beijing Forestry University, Beijing, China, 2010. [Google Scholar]
- Zhang, X.; Wu, Q.; Lin, S.; Zhang, Z.; Wang, Z.; Wang, Q.; Yan, X.; Bendahmane, M.; Bao, M.; Fu, X. Regeneration and Agrobacterium-mediated genetic transformation in Dianthus chinensis. Sci. Hortic. 2021, 287, 110279. [Google Scholar] [CrossRef]
- Heuser, C.W.; Apps, D.A. In vitro plantlet formation from flower petal explants of Hemerocallis cv. Chipper Cherry. Can. J. Bot. 1976, 54, 616–618. [Google Scholar] [CrossRef]
- Li, Z.; Mize, K.; Campbell, F. Regeneration of daylily (Hemerocallis) from young leaf segments. Plant Cell Tissue Organ Cult. 2010, 102, 199–204. [Google Scholar] [CrossRef]
- Gao, J. Optimization of Regeneration System and Establishment of Agrobacterium-Mediated Transformation System of Daylily. Master’s Dissertation, Sichuan Agricultural University, Ya’an, China, 2012. [Google Scholar]
- Rodriguez-Enriquez, M.J.; Grant-Downton, R.T. A new day dawning: Hemerocallis (daylily) as a future model organism. AoB Plants 2013, 5, pls055. [Google Scholar] [CrossRef]
- Jin, L.M.; Zhou, Y.Z.; Guo, Z.H.; Huang, B.J. Effect of inbred, hybrid and different cultivation enviroments on seed setting characteristics of Hemerocallis hybrid. Hubei Agric. Sci. 2012, 51, 2760–2763. [Google Scholar] [CrossRef]
- Aziz, A.N.; Sauvé, R.J.; Zhou, S. Genetic transformation of Stella de Oro daylily by particle bombardment. Can. J. Plant Sci. 2003, 83, 873–876. [Google Scholar] [CrossRef]
- Ni, D.; Liang, J.; Gao, M.; Zhong, R.; Tan, Y.; Liu, X.; Yin, D.; Zhang, Z. Daylily glyoxalase gene cloning and pollen-tube pathway transformation. Plant Physiol. J. 2020, 56, 171–179. [Google Scholar] [CrossRef]
- Wang, X.X. The Plant Regeneration and Transformation of CHS Gene by Grobacteria-Mediated in Hemerocallis hybrida. Master’s Dissertation, Gansu Agricultural University, Lanzhou, China, 2013. [Google Scholar]
- Srinivasan, C.; Dardick, C.; Callahan, A.; Scorza, R. Plum (Prunus domestica) trees transformed with poplar FT1 result in altered architecture, dormancy requirement, and continuous flowering. PLoS ONE 2012, 7, e40715. [Google Scholar] [CrossRef]
- Heller, W.P.; Ying, Z.; Davenport, T.L.; Keith, L.M.; Matsumoto, T.K. Identification of members of the Dimocarpus longan Flowering Locus T gene family with divergent functions in fowering. Trop. Plant Biol. 2014, 7, 19–29. [Google Scholar] [CrossRef]
- Zhang, L.; Zhang, F.; Zhou, X.; Poh, T.X.; Xie, L.; Shen, J.; Yang, L.; Song, S.; Yu, H.; Chen, Y. The tetratricopeptide repeat protein OsTPR075 promotes heading by regulating florigen transport in rice. Plant Cell 2022, 34, 3632–3646. [Google Scholar] [CrossRef]
- Kinoshita, T.; Ono, N.; Hayashi, Y.; Morimoto, S.; Nakamura, S.; Soda, M.; Kato, Y.; Ohnishi, M.; Nakano, T.; Inoue, S.; et al. FLOWERING LOCUS T regulates stomatal opening. Curr. Biol. 2011, 21, 1232–1238. [Google Scholar] [CrossRef] [PubMed]
- Jing, S.; Sun, X.; Yu, L.; Wang, E.; Cheng, Z.; Liu, H.; Jiang, P.; Qin, J.; Begum, S.; Song, B. Transcription factor StABI5-like 1 binding to the FLOWERING LOCUS T homologs promotes early maturity in potato. Plant Physiol. 2022, 189, 1677–1693. [Google Scholar] [CrossRef] [PubMed]
- Murashige, T.; Skoog, F. A revised medium for rapid growth and bio assays with tobacco tissue cultures. Physiol. Plant. 1962, 15, 473–497. [Google Scholar] [CrossRef]
- MacWilliams, M.P.; Liao, M.K. Luria Broth (LB) and Luria Agar (LA) media and their uses protocol. Am. Soc. Microbiol. 2006, 1–4. [Google Scholar]
- Chen, H.; Nelson, R.; Sherwood, J. Enhanced recovery of transformants of Agrobacterium tumifaciens after freeze-thaw transformation and drug selection. Biotechniques 1994, 16, 664–670. [Google Scholar]
- Aljanabi, S.; Martinez, I. Universal and rapid salt-extraction of high quality genomic DNA for PCR-based techniques. Nucleic Acids Res. 1997, 25, 4692–4693. [Google Scholar] [CrossRef]
- Liu, Y.; Gao, Y.; Yuan, L.; Zhang, Q. Functional characterization and spatial interaction of TERMINAL FLOWER 1 in Hemerocallis. Sci. Hortic. 2019, 253, 154–162. [Google Scholar] [CrossRef]
- Zhang, Y.; Sun, J.; Xia, H.; Zhao, C.; Hou, L.; Wang, B.; Li, A.; Chen, M.; Zhao, S.; Wang, X. Characterization of peanut phytochromes and their possible regulating roles in early peanut pod development. PLoS ONE 2018, 13, e0198041. [Google Scholar] [CrossRef] [PubMed]
- Veluthambi, K.; Krishnan, M.; Gould, J.H.; Smith, R.H.; Gelvin, S.B. Opines stimulate induction of the vir genes of the Agrobacterium tumefaciens Ti plasmid. J. Bacteriol. 1989, 171, 3696–3703. [Google Scholar] [CrossRef] [PubMed]
- Krishnamohan, A.; Balaji, V.; Veluthambi, K. Efficient vir gene induction in Agrobacterium tumefaciens requires virA, virG, and vir box from the same Ti plasmid. J. Bacteriol. 2001, 183, 4079–4089. [Google Scholar] [CrossRef]
- Ebrahimzadegan, R.; Maroufi, A. In vitro regeneration and Agrobacterium-mediated genetic transformation of Dragon’s Head plant (Lallemantia iberica). Sci. Rep. 2022, 12, 1784. [Google Scholar] [CrossRef] [PubMed]
- Haida, Z.; Sinniah, U.R.; Nakasha, J.J.; Hakiman, M. Shoot induction, multiplication, rooting and acclimatization of black turmeric (Curcuma caesia Roxb.): An important and endangered Curcuma species. Horticulturae 2022, 8, 740. [Google Scholar] [CrossRef]
- Das, D.K.; Rahman, A. Phenolic compositions of litchi shoot tips and zygotic embryos collected in different months and their effects on the explant browning and its control. Adv. Anthropol. 2016, 6, 73–92. [Google Scholar] [CrossRef]
- Lux-Endrich, A.; Treutter, D.; Feucht, W. Influence of nutrients and carbohydrate supply on the phenol composition of apple shoot cultures. Plant Cell Tissue Organ Cult. 2000, 60, 15–21. [Google Scholar] [CrossRef]
- Gbadamosi, I.T.; Egunyomi, A. Micropropagation of Plumbago zeylanica L. (Plumbaginaceae) in Ibadan, Southwestern, Nigeria. J. Med. Plants Res. 2010, 4, 293–297. [Google Scholar]
- Siddique, I.; Javed, S.B.; Al-Othman, M.R.; Anis, M. Stimulation of in vitro organogenesis from epicotyl explants and successive micropropagation round in Cassia angustifolia Vahl.: An important source of sennosides. Agrofor. Syst. 2013, 87, 583–590. [Google Scholar] [CrossRef]
- Rajoriya, P.; Singh, V.K.; Jaiswal, N.; Lall, R. Optimizing the effect of plant growth regulators on in vitro micro propagation of Indian red banana (Musa acuminata). J. Pharmacogn. Phytochem. 2018, 7, 628–634. [Google Scholar]
- De Klerk, G.J.; Hanecakova, J.; Jasik, J. The role of cytokinins in rooting of stem slices cut from apple microcuttings. Plant Biosyst. 2001, 135, 79–84. [Google Scholar] [CrossRef]
- Huang, T.; Zhang, H.; Zhao, R.; Zhu, Z. Establishing an efficient regeneration system for tissue culture in Bougainvillea buttiana ‘Miss Manila’. Plants 2022, 11, 2372. [Google Scholar] [CrossRef] [PubMed]
- Confalonieri, M.; Balestrazzi, A.; Bisoffi, S. Genetic transformation of Populus nigra by Agrobacterium tumefaciens. Plant Cell Rep. 1994, 13, 256–261. [Google Scholar] [CrossRef]
- Yuan, X.; Wang, Z.; Liu, J.; She, J. Development of a plant regeneration system from seed-derived calluses of centipedegrass [Eremochloa ophiuroides (Munro.) Hack]. Sci. Hortic. 2009, 120, 96–100. [Google Scholar] [CrossRef]
- Chhabra, G.; Chaudhary, D.; Sainger, M.; Jaiwal, P.K. Genetic transformation of Indian isolate of Lemna minor mediated by Agrobacterium tumefaciens and recovery of transgenic plants. Physiol. Mol. Biol. Plants 2011, 17, 129–136. [Google Scholar] [CrossRef]
- Chen, X.A.; He, X.; Zhang, M.; Mao, X.M.; Li, Y. Q An efficient genetic transformation system for Chinese medicine fungus Tolypocladium ophioglossoides. J. Microbiol. Methods 2020, 176, 106032. [Google Scholar] [CrossRef] [PubMed]
- Wang, X.; Zhou, F.; Liu, J.; Liu, W.; Zhang, S.; Li, D.; Song, J.; Wang, R.; Yang, Y. Establishment of efficient callus genetic transformation system for Pyrus armeniacaefolia. Sci. Hortic. 2021, 289, 110429. [Google Scholar] [CrossRef]
- Chen, J.R.; Chen, Y.B.; Ziemiańska, M.; Liu, R.; Deng, Z.N.; Niedźwiecka-Filipiak, I.; Li, Y.L.; Jiao, J.X.; Xiong, X.Y. Co-expression of MtDREB1C and RcXET enhances stress tolerance of transgenic China rose (Rosa chinensis Jacq.). J. Plant Growth Regul. 2016, 35, 586–599. [Google Scholar] [CrossRef]
- Liu, G.; Yuan, Y.; Jiang, H.; Bao, Y.; Ning, G.; Zhao, L.; Zhou, X.; Zhou, H.; Gao, J.; Ma, N. Agrobacterium tumefaciens-mediated transformation of modern rose (Rosa hybrida) using leaf-derived embryogenic callus. Hortic. Plant J. 2021, 7, 359–366. [Google Scholar] [CrossRef]
- Bannikova, M.A.; Gorbatyuk, I.R.; Hnatiuk, I.S.; Malysheva-Otto, L.V.; Duplij, V. Effect of Ceftriaxone and Timentin antibiotics on morphogensis in the in vitro culture of bread wheat Triticum aestivum L. Biopolym. Cell 2016, 32, 367–376. [Google Scholar] [CrossRef]
- Zhang, H.; Wang, G.; Qiao, Y.; Chen, C. Effects of Timentin and other β-Lactam antibiotics on callus induction, shoot regeneration, and rooting in Anthurium andraeanum Linden ex Andre. In Vitro Cell. Dev. Biol. Plant 2017, 53, 219–225. [Google Scholar] [CrossRef]
- John, E.; Maqbool, A.; Malik, K.A. Optimization of Agrobacterium tumefaciens mediated transformation in Populus deltoides. Pak. J. Bot. 2014, 46, 1079–1086. [Google Scholar]
- Movahedi, A.; Zhang, J.; Amirian, R.; Zhuge, Q. An efficient Agrobacterium-mediated transformation system for Poplar. Int. J. Mol. Sci. 2014, 15, 10780–10793. [Google Scholar] [CrossRef]
- Li, S.; Zhen, C.; Xu, W.; Wang, C.; Cheng, Y. Simple, rapid and efficient transformation of genotype Nisqually-1: A basic tool for the first sequenced model tree. Sci. Rep. 2017, 7, 2638. [Google Scholar] [CrossRef]
- Li, X.; Li, H.; Zhao, Y.; Zong, P.; Zhan, Z.; Piao, Z. Establishment of a simple and efficient Agrobacterium-mediated genetic transformation system to Chinese Cabbage (Brassica rapa L. ssp. pekinensis). Hortic. Plant J. 2021, 7, 117–128. [Google Scholar] [CrossRef]
- Ratjens, S.; Mortensen, S.; Kumpf, A.; Bartsch, M.; Winkelmann, T. Embryogenic callus as target for efficient transformation of Cyclamen persicum enabling gene function studies. Front. Plant Sci. 2018, 9, 1035. [Google Scholar] [CrossRef]
- Tan, J.; Lin, L.; Luo, H.; Zhou, S.; Zhu, Y.; Wang, X.; Miao, L.; Wang, H.; Zhang, P. Recent progress in the regeneration and genetic transformation system of cucumber. Appl. Sci. 2022, 12, 7180. [Google Scholar] [CrossRef]
- Nandakumar, R.; Chen, L.; Rogers, S.M.D. Factors affecting the Agrobacterium-mediated transient transformation of the wetland monocot, Typha latifolia. Plant Cell Tissue Organ Cult. 2004, 79, 31–38. [Google Scholar] [CrossRef]
- Godoy-Hernández, G.; Berzunza, E.A.; Concha, L.C.; Miranda-Ham, M.d.L. Agrobacterium-mediated transient transformation of marigold (Tagetes erecta). Plant Cell Tissue Organ Cult. 2006, 84, 365–368. [Google Scholar] [CrossRef]
- Chen, Y.; Hou, X.; Zheng, Y.; Lyu, Y. The establishment of a genetic transformation system and the acquisition of transgenic plants of oriental hybrid lily (Lilium L.). Int. J. Mol. Sci. 2023, 24, 782. [Google Scholar] [CrossRef]

| Procedure | Medium Composition |
|---|---|
| Seed germination | MS + 1.0 mg·L−1 6-BA + 1.0 mg·L−1 KT + 0.5 mg·L−1 IBA + 30 g·L−1 sucrose + 7.6 g·L−1 agarose |
| Callus induction | MS + (1.0, 1.5, 2.0, 2.5, 3.0, 3.5, 4.0) mg·L−1 6-BA + (0.1, 0.2, 0.3) mg·L−1 NAA + 30 g·L−1 sucrose + 7.6 g·L−1 agarose |
| Callus proliferation | MS + (1.0, 1.5, 2.0, 2.5, 3.0, 3.5, 4.0) mg·L−1 6-BA + (0.1, 0.2, 0.3) mg·L−1 NAA + 0.1 mg·L−1 2,4-D + 30 g·L−1 sucrose + 7.6 g·L−1 agarose |
| Callus differentiation | MS + (0, 0.5, 1.0, 1.5, 2.0) mg·L−1 6-BA + 0.2 mg·L−1 NAA + 30 g·L−1 sucrose + 7.6 g·L−1 agarose |
| Rooting | 1/2MS + 0.2 mg·L−1 NAA + 30 g·L−1 sucrose + 7.6 g·L−1 agarose |
| Procedure | Medium Composition |
|---|---|
| Pre-cultivation | MS + 1.0 mg·L−1 6-BA + 0.2 mg·L−1 NAA + 30 g·L−1 sucrose + 7.6 g·L−1 agarose |
| Agrobacterium infection | MS + (0, 50, 100, 150, 200) μmol·L−1 AS + 30 g·L−1 sucrose |
| Co-cultivation | MS + 1.0 mg·L−1 6-BA + 0.2 mg·L−1 NAA + (0, 50, 100, 150, 200) μmol·L−1 AS + 30 g·L−1 sucrose + 7.6 g·L−1 agarose |
| Resting | MS + 1.0 mg·L−1 6-BA + 0.2 mg·L−1 NAA + (0, 100, 200, 300, 400) mg·L−1 TMT + 20 g·L−1 sucrose + 7.6 g·L−1 agarose |
| Selection | MS + 1.0 mg·L−1 6-BA + 0.2 mg·L−1 NAA + (0, 3, 6, 9, 12) mg·L−1 Hyg + (0, 100, 200, 300, 400) mg·L−1 TMT+ 30 g·L−1 sucrose + 7.6 g·L−1 agarose |
| Rooting | 1/2MS + 0.2 mg·L−1 NAA + 30 g·L−1 sucrose + 7.6 g·L−1 agarose |
| Experimental Treatment | Seed Contamination Rate (%) | Seed Germination Rate (%) |
|---|---|---|
| M1 | 92.2 ± 6.9 a | 32.6 ± 4.6 c |
| M2 | 68.9 ± 10.2 b | 74.5 ± 10.7 b |
| M3 | 6.7 ± 6.7 c | 98.0 ± 3.9 a |
| 6-BA (mg·L−1) | NAA (mg·L−1) | Number of Calli per Medium | Induction Rate (%) |
|---|---|---|---|
| 1.5 | 0.1 | 11.3 ± 1.5 efg | 37.8 ± 5.1 efg |
| 1.5 | 0.2 | 13.7 ± 2.5 ef | 45.6 ± 8.4 ef |
| 1.5 | 0.3 | 8.7 ± 2.1 g | 28.9 ± 6.9 g |
| 2.0 | 0.1 | 15.7 ± 1.5 def | 52.2 ± 5.1 def |
| 2.0 | 0.2 | 15.3 ± 1.5 def | 51.1 ± 5.1 def |
| 2.0 | 0.3 | 12.7 ± 1.5 ef | 42.2 ± 5.1 ef |
| 2.5 | 0.1 | 18.3 ± 1.5 cd | 61.1 ± 5.1 cd |
| 2.5 | 0.2 | 15.7 ± 3.0 de | 52.2 ± 1.0 de |
| 2.5 | 0.3 | 14.7 ± 2.1 de | 48.9 ± 6.9 de |
| 3.0 | 0.1 | 26.3 ± 1.5 ef | 87.8 ± 5.1 ef |
| 3.0 | 0.2 | 24.0 ± 1.7 bc | 80.0 ± 5.8 bc |
| 3.0 | 0.3 | 21.0 ± 2.7 bc | 70.0 ± 8.8 bc |
| 3.5 | 0.1 | 28.5 ± 5.8 a | 95.6 ± 1.9 a |
| 3.5 | 0.2 | 26.7 ± 2.5 b | 85.6 ± 5.1 b |
| 3.5 | 0.3 | 22.7 ± 2.1 bc | 75.6 ± 6.9 bc |
| 4.0 | 0.1 | 25.3 ± 1.5 bc | 84.4 ± 5.1 bc |
| 4.0 | 0.2 | 21.0 ± 2.7 cd | 70.0 ± 8.8 cd |
| 4.0 | 0.3 | 22.7 ± 2.1 bc | 75.6 ± 6.9 bc |
| 6-BA (mg·L−1) | NAA (mg·L−1) | Number of Calli Forming Shoots | Regeneration Rate (%) |
|---|---|---|---|
| 0.5 | 0.2 | 22.0 ± 2.0 ab | 73.3 ± 6.7 ab |
| 1.0 | 0.2 | 25.3 ± 3.1 a | 84.4 ± 10.2 a |
| 1.5 | 0.2 | 18.7 ± 0.6 bc | 62.2 ± 1.9 bc |
| 2.0 | 0.2 | 15.7 ± 1.5 cd | 52.2 ± 5.1 cd |
| 2.5 | 0.2 | 12.7 ± 2.5 d | 42.2 ± 8.4 d |
| 3.0 | 0.2 | 8.3 ± 1.2 e | 27.8 ± 3.9 e |
| Replicate | Number of Explants | Transformation Rate (%) | Positive Rate (%) |
|---|---|---|---|
| 1 | 43 | 11.6 | 25.0 |
| 2 | 50 | 12.0 | 33.3 |
| 3 | 41 | 12.2 | 40.0 |
| Average | 11.9 | 32.8 |
Disclaimer/Publisher’s Note: The statements, opinions and data contained in all publications are solely those of the individual author(s) and contributor(s) and not of MDPI and/or the editor(s). MDPI and/or the editor(s) disclaim responsibility for any injury to people or property resulting from any ideas, methods, instructions or products referred to in the content. |
© 2025 by the authors. Licensee MDPI, Basel, Switzerland. This article is an open access article distributed under the terms and conditions of the Creative Commons Attribution (CC BY) license (https://creativecommons.org/licenses/by/4.0/).
Share and Cite
Du, J.; Shi, J.; Zhang, N.; Liu, Y.; Liu, W. Preliminary Establishment of an Efficient Regeneration and Genetic Transformation System for Hemerocallis middendorffii Trautv. & C. A. Mey. Horticulturae 2025, 11, 417. https://doi.org/10.3390/horticulturae11040417
Du J, Shi J, Zhang N, Liu Y, Liu W. Preliminary Establishment of an Efficient Regeneration and Genetic Transformation System for Hemerocallis middendorffii Trautv. & C. A. Mey. Horticulturae. 2025; 11(4):417. https://doi.org/10.3390/horticulturae11040417
Chicago/Turabian StyleDu, Jinxue, Jingbo Shi, Nan Zhang, Yingzhu Liu, and Wei Liu. 2025. "Preliminary Establishment of an Efficient Regeneration and Genetic Transformation System for Hemerocallis middendorffii Trautv. & C. A. Mey." Horticulturae 11, no. 4: 417. https://doi.org/10.3390/horticulturae11040417
APA StyleDu, J., Shi, J., Zhang, N., Liu, Y., & Liu, W. (2025). Preliminary Establishment of an Efficient Regeneration and Genetic Transformation System for Hemerocallis middendorffii Trautv. & C. A. Mey. Horticulturae, 11(4), 417. https://doi.org/10.3390/horticulturae11040417

